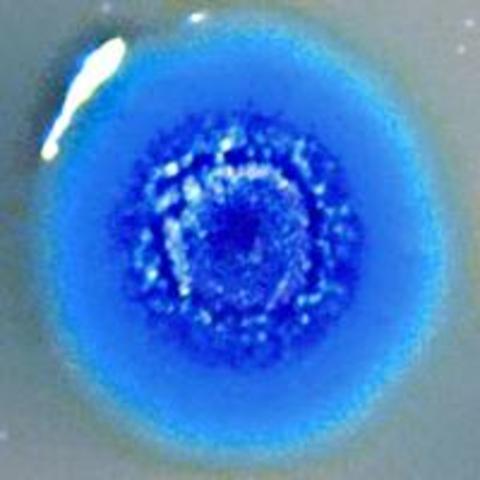
Researchers at the J. Craig Venter Institute create the first synthetic cell.

-
Scientists realized that genes were linked with diseases passed from parent to offspring, and realized some famalies were more likely to get certain diseases.
-
Viruses that affected your bacteria are discovered
-
Penicillin is discovered, a monumental step in curing disease.
-
Two scientists complete their study of the structure of DNA, which gave people everywhere a greater understanding of its function.
-
The first ever succesful cloning takes place between two mice.
-
This changes the way many vegetables and food are grown, because of its supposeedly safe and more affective way of growing plants.
-
This allows for many hereditary diseases to be treated in the future and truely opens peoples eyes about the possibility of medicine.
-
This sparks a national debate over the topic of GMOs and labeling GMOs.
-
This shows people what genetically makes them them, and what they are made up of.
-
This allows scientists to really dig deep and explore the cell, and cure disease from the smallest part of the body.
A list shows items. A timeline shows sequence.
Use Timetoast to make dates, milestones, and turning points easier to understand in a clear visual format. Timetoast is a timeline maker for work, school, research, and stories.